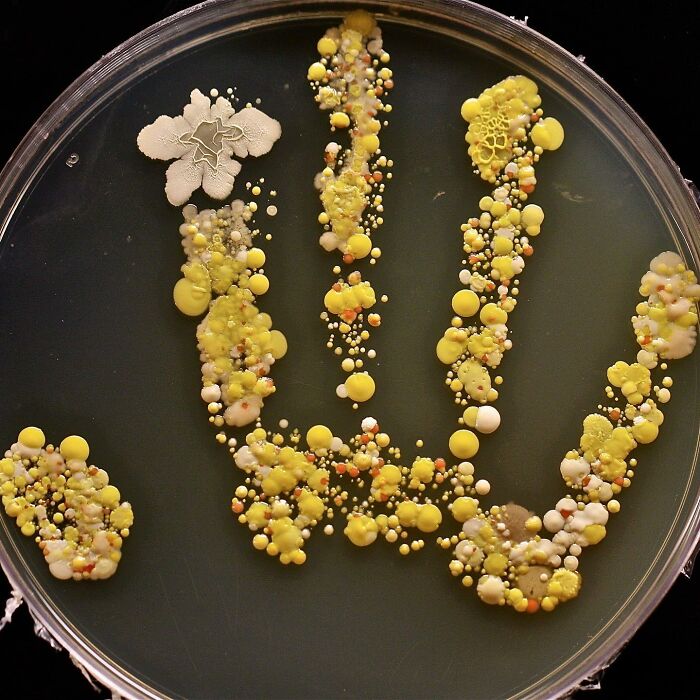
69 Unusual Medical Photos That Land Somewhere In Between Science And Nightmare

Despite the fact that we quite literally embody our own bodies, they can still be a source of horror in the right (or wrong) circumstances. It’s one of the reasons roughly 4% of US medical students drop out, not due to poor grades but the realization that this maybe isn’t for them.
We’ve gathered some unsettling, creepy but perhaps still interesting pictures about the unusual things that can go on in and outside of the human body. Be warned, some of these images can be unpleasant. Otherwise, settle in as you scroll through, upvote your favorites and be sure to share your thoughts in the comments down below.
#1 Doctors Successfully 3D Printed This Cancer Patient A New Nose, Planted It On His Forearm To Then Re-Implant It Where It Belongs
You often hear that they’re doing wonderful things with science these days, and when you hear that someone who lost their nose to cancer had one printed and re-grown for them, you have to admit that it’s true.
The new nose was grown by creating a 3D-printed mold that was then transferred under the skin of her forearm.
There, it grew blood vessels and was eventually able to be transplanted onto her face where it belongs.
The patient had been receiving cancer treatment for squamous cell carcinoma present in her nasal cavity.
The patient, undergoing radiation and chemotherapy in 2013 for nasal cancer, lost a large portion of her nose. After several failed nasal reconstructions, the use of bespoke biomaterials was proposed.
They recreated her actual nose by 3D printing one made from biomaterial, in collaboration with a manufacturer of bone device.
They overcame the lack of blood vessels by attaching it to her arm first, then once they were established and properly revascularized via the arm’s skin vessels after approximately 2 months, it was ready to be transplanted to the nasal region by micro-surgery.
Team effort of Claudius Regaud Institute and CHU university hospital of Toulouse, France.

Image source: medicaltalks
#2 Transforming Curves: From Struggle To Strength – Witness The Journey Of Scoliosis
Scoliosis is characterized by a lateral deviation and rotational deformity of the spine, resulting in an abnormal sideways curvature. It can manifest in different regions of the vertebral column and exhibit varying degrees of severity.
This 13-year-old’s scoliosis was progressing so rapidly that major spinal surgery was her only treatment option. In just over six months, her curve progressed from what was initially 49-degree to a 99-degree curve. The girl now has a combination of titanium rods and screws around her spine. Luckily she fully recovered and got back to her normal activities.
While scoliosis can be caused by conditions such as cerebral palsy and muscular dystrophy, the cause of most scoliosis is unknown. About 3% of adolescents have scoliosis.
Treatment depends on the degree of curve, location, and cause. Minor curves may simply be watched periodically. Management options may involve close observation, utilization of orthotic devices (e.g., braces) for stabilization, or, in severe cases, surgical intervention aimed at rectifying the curvature and achieving spinal stability. The brace must be fitted to the person and used daily until growing stops.
Surgery is usually recommended by orthopedists for curves with a high likelihood of progression (i.e., greater than 45 to 50° of magnitude), curves that would be cosmetically unacceptable as an adult, curves in people with spina bifida and cerebral palsy that interfere with sitting and care, and curves that affect physiological functions such as breathing. To completely straighten a scoliotic spine is usually impossible, but for the most part, significant corrections are achieved.
Credit: Isabel Dayman, Mobile.abc.net.au

Image source: medicaltalks
#3 Genuine MRI Scans Of Human Babies In The Womb
Possessing menacing eyes and devilish grins, you would be forgiven for assuming these were just aliens from a Hollywood sci-fi blockbuster.
These images were circulating on social media apps and while some suggest they have been traumatised by viewing such discomforting images, others seem to find them comical.
Some users even believed the fetus was an extra-terrestrial being.
Yet, believe it or not, they are not fake.
Instead, they are genuine MRI scans of human babies in the womb.
MRI scans are different to ultrasounds. Parents are not regularly offered MRI throughout their pregnancy and will typically only have the scan if there is a concern for the child’s growth and development.
For example, they can help define and detect neck, thoracic, abdominal and spinal malformations in fetuses.
When used during pregnancy, however, MRIs can produce a very life-like image of their baby.
The detailed black and white images burst the bubble of many parents who blindly believe their tiny tot is going to be adorable through and through.
One user said MRIs are discouraged during pregnancy because ‘people would realise they’re incubating nightmare demons and would be rightfully terrified’.
We can confirm these images are authentic and real.
MRI uses magnetic fields and radio waves to produce detailed images of the inside of the body.
The eyes and brain have high levels of ‘signal’ — a radio wave — which causes them to appear brighter and stand out on the scan.
Other parts of the body give off lower levels, and therefore appear darker.

Image source: medicaltalks
#4 Dinner Is Served — Petri Dish With A Colony Of Bacteria On A Hand!! This Is The Handprint Of An 8-Year-Old Boy Covered In Bacteria
The boy came in from playing outside, and his mom decided to put his hand print inside a large Petri dish, incubated it for two days, and ended up with a colorful germ garden!
Consider for a moment what you’ve touched today. After all, our hands do all sorts of things for us – they open doors, handle money at the wet market, hold on to poles on public buses and trains, all the time while grasping our phones. They often also act as the barrier between our coughs and the rest of the world.
Up to 80% of all infections are transmitted by hands.
The colony on the hand would consist of various bacteria, potentially including both gram-positive and gram-negative species. These bacteria could belong to different genera and species, such as Staphylococcus, Streptococcus, or Escherichia coli, among others. The colony may exhibit different morphological characteristics, such as size, shape, and coloration, depending on the specific bacteria present.
Additionally, the colony might demonstrate characteristics indicative of bacterial growth, such as a visible texture or elevation. It could display features like smoothness, roughness, or irregularity. The Petri dish would provide a suitable environment for these bacteria to multiply, as it would contain a culture medium that supports their growth and sustenance.
Image source: medicaltalks
#5 Surgeon Finds 27 Contact Lenses Lost In Woman’s Eye
A 67-year-old woman scheduled for routine cataract surgery thought it was just dry eye and old age causing her discomfort, she told her surgeons.
But what doctors found to be the real cause of her discomfort was much more concerning: 27 disposable contact lenses, stuck in the woman’s right upper eyelid.
An anesthetist at the hospital was beginning to numb her eye for surgery when he found the first cluster of contacts.
He put a speculum into the eye to hold the eye open as he put the anesthetic in, when he noticed a blue foreign body emerging from the top eyelid.
That mass was a clump of 17 lenses (bottom picture).
On closer inspection, 10 more lenses were discovered floating around loose.
The lenses were clumped together in a “blueish mass” and were bound together by mucus.
The woman had been wearing monthly disposable contact lenses for 35 years, but it’s unclear how long they had been gathering in her eye. Sometimes, she told the surgeons, when she would try to remove a contact from that eye, she couldn’t find it.
The patient had just figured she’d dropped it somewhere, but it was actually getting stuck in her eye with the others.
Two weeks after removing the lenses her eyes felt a lot more comfortable.
Source – the British Medical Journal.

Image source: medicaltalks
#6 Pediatric Heart Transplantation

Image source: medical_pedia
#7 Plica Fimbriata Refers To The Small Folds In The Membrane On The Underside Of Your Tongue
The folds tend to run parallel to, and on either side of your frenulum. The frenulum is the web of tissue that connects your tongue to the bottom of your mouth. These growths are harmless. They are normal residual tissue not completely reabsorbed by the body during the development and growth of the tongue.
Sometimes they can get caught in your teeth. If one of these bumps comes off, it can leave an open sore that’s vulnerable to infection. For most infections you may just need to use an antieptic mouthwash for a few days to keep the area clean.

Image source: medical_pedia
#8 Hundreds Of Nerve Tumors That Form Soft Bumps On/Under The Skin
This very specific clinical finding is associated with neurofibromatosis type 1 (NF1), also called von Recklinghausen’s disease, a rare genetic disorder characterized by the development of multiple noncancerous (benign) tumors of nerves and skin (neurofibromas) and areas of abnormally decreased or increased coloration (hypo- or hyperpigmentation) of the skin. It is one of the most common genetic disorders and affects 1 in 3,500. Adults develop neurofibromas, which are noncancerous (benign) peripheral nerve sheath tumors that are usually located on or just under the skin. Many have also multiple café-au-lait spots, which are flat patches on the skin that are darker than the surrounding area. NF-1 is caused by a mutation of a gene on the long arm of chromosome 17 which encodes a protein known as neurofibromin, which is a negative regulator of the Ras oncogene signal transduction pathway. When Ras isn’t regulated, it is overexpressed. These are a family of proteins that are involved in cellular signal transduction. A cascade effect occurs when ras is “switched on” by incoming signals, leading to activation of other proteins, which, in turn, activate genes responsible for cell growth and differentiation, hence leading to neurofibromas. Due to their benign nature, neurofibromas should be surgically excised only when symptomatic.

Image source: medical_pedia
#9 Extreme Case Of Hydrocephalus In A Pediatric Patient
Hydrocephalus is a pathology characterized by dilation of the cerebral ventricles, normally caused by the obstruction of the flow of cerebrospinal fluid (CSF), or by an imbalance between its production and absorption, in addition there is inflammatory response, neuronal damage and destruction of periventricular axons.
Hydrocephalus is cataloged in two ways. Depending on the origin, it can be congenital or acquired; and in relation to the CSF flow, this pathology is classified as communicating (i.e. CSF can exit the ventricular system, but the fluid is not absorbed readily, or there is too much fluid to be absorbed) or non-communicating (i.e. CSF cannot exit the ventricular system, and thus there is obstruction to CSF absorption, resulting in an increased pressure inside the brain). Symptoms of hydrocephalus may include an unusually large head with thin, transparent scalp, bulging forehead with increased spaces between the bones of the skull (fontanelles), and a downward gaze.
The most common congenital cause is the obstruction or narrowing (stenosis) of the cerebral aqueduct — the long, narrow passageway between the third and fourth ventricles of the brain. It can also be caused by infections, hemorrhage or a tumor.
The condition is pretty rare and can be easily detected early in pregnancy by ultrasound which does not necessarily shows the obstruction but detects an abnormal collection of fluid.
These kids are treated after birth by either inserting a shunt, small flexible plastic tube that diverts excess CSF from the brain to another part of the body where the fluid can be reabsorbed; or by an endoscopic ventriculostomy, where a small hole is made in the floor of the third ventricle, allowing the CSF to bypass the obstruction and flow toward other areas where reabsorption can happen.

Image source: medical_pedia
#10 These X-Ray Images Show Severe Skull And Facial Injuries Following A Gunshot From An AK-47

Image source: medicaltalks
#11 Guy Comes In With Amputation Of The Distal Half Of The Hand Resulting In Complete Separation Of Four Fingers At The Level Of Metacarpals
What do you think caused this injury?
Let your mind go wild on this one.
A. Machete attack
B. Chainsaw
C. Motorcycle crash
D. Manual meat slicer
E. Bear attack
F. Hydraulic press cutting machine
Edit: Answer – B!
Patient presented with traumatic amputation of the distal half of the hand following a work-related chainsaw accident. Full detachment of all four fingers at the metacarpal level.
Obviously, urgent medical evaluation and surgical intervention is needed, but first, let’s just do an x-ray to see if it’s broken, just to make sure.

Image source: medicaltalks
#12 More Than 200 Bladder Stones Found In An 81-Year-Old Man
The patient in this case is an elderly man who has had urinary stasis obstruction for a long time due to benign prostate hyperplasia (BPH).
Due to urinary stasis, numerous stones have formed inside the bladder.
Given the large number of bladder stones and the patient’s symptoms, the management plan involved a multidisciplinary approach, including Transurethral resection of the prostate (TURP): To alleviate bladder outlet obstruction caused by BPH and reduce the risk of recurrent stone formation, an open bladder stone removal, which led to the removal of a mind-blowing number of over 200 stones!
Bladder stones are solid calculi that are primarily found in the urinary bladder. While often calcified, they may also be composed of non-calcific material.
Urinary stasis, such as BPH or neurogenic bladder disorder, is the primary cause. Most such stones are newly formed in the bladder. Some come from the kidneys either as a stone or a sloughed papilla.
Any foreign body left in the bladder that is not spontaneously expelled will eventually form layers of stone material and develop into calculus. In 50% of cases the stone composition is uric acid.
In regards to surgical therapy, endoscopic surgery is used.
Cystolitholapaxy (to break up bladder stones into smaller pieces and remove them), can be achieved by disruptive or ablative therapy, including lasers, pneumatic-powered mechanical contact jackhammer, ultrasound, and direct mechanical crushing with a lithotrite.
Extracorporeal shockwave lithotripsy is also used.
In some cases of extremely large bladder stones or prostates, open suprapubic surgery is done. This allows for the removal of the intact stone, followed by an open prostatectomy (for prostates more than 75 g in size).
The advantage of an open suprapubic cystostomy for bladder stone removal is the reduced surgery time (half the time compared to endoscopic means), easy removal of large or multiple stones, ability to remove stones that might be difficult or hard to fragment with endoscopic treatments and the ability to handle stones that are stuck to the bladder lining.

Image source: medicaltalks
#13 This Man Has Miraculously Survived After Apparently Hammering Three 10cm (4-Inch) Nails Into His Own Head
The 69-year-olds x-rays revealed that the nails had been hammered through his skull and into his brain – but he made a full recovery following a surgery and a 3-months stay at the hospital.
He claimed that he hammered the nails in himself and was very insistent to the doctors that the police were not called in relation to his injuries.
He made a full recovery with no major neurological deficit.

Image source: medicaltalks
#14 You Arrive On Scene Of A Residential Home And Find A Pet Snake Constricting Around Someone’s Hand

Image source: medicaltalks
#15 Neurosurgeon Removes Live 8cm Long Worm From Woman’s Brain!!
Scientists last month published an unprecedented case, where they found and extracted a live parasitic worm from the brain of a 64-year-old Australian woman.
The neurosurgeon found and removed the parasite with forceps during a biopsy, from within the lesion shown on the MRI (light gray area).
“I used tumor-holding forceps and lifted out something that I definitely was not expecting: a linear, squiggling line, and my junior doctor said, ‘is that an artery?’, because that’s what it looked like. And I said, ‘it’s not an artery, we’re nowhere near any artery!’ And I noticed it was moving and I went, ‘just get it out of my forceps!’ So we rapidly put it in a pathology pot, and it was a vigorously wriggling worm.”
Symptomatically, weeks of abdominal pain and diarrhea led to night sweats and a dry cough, but evolved towards problems like forgetfulness and depression, presumably as the worm׳s activities kept affecting different parts of the brain.
The worm was some 8 centimeters (just over 3 inches) long and is a rare parasite called Ophidascaris Robertsi. This is a type of Roundworm (Helminth). This roundworm usually lives in a Carpet Python. The eggs of the worm are around the snakes’ faecal droppings, which infect the grass. This grass containing the eggs, are eaten by small mammals, who are then eaten by the Carpet Python. This is how this worm gets cycled between its two hosts. This woman became an ‘accidental host’. She lived near the carpet python habitat and while foraging the native vegetation for cooking, she ingested the worm eggs. The worm developed in her intestine and travelled via blood circulation to her brain.
In response, the body produces inflammation around the worm and as a result, an area of inflammatory tissue or granuloma develops in the brain. Depending upon the affected location, it can cause a multitude of symptoms such as pressure symptoms – headache, vomiting, visual blurring, confusion, altered sensorium, cognitive symptoms – forgetfulness, problems in understanding, calculations, disorientation, seizures and epilepsy – due to irritation of the brain by inflammatory tissue.

Image source: medicaltalks
#16 Man With 3-Inch Nail In Skull Goes To Hospital After Two Days… But Can’t Remember How It Got There
This man went to his local hospital and told them he had a “headache for the past 2 days”.
The Emergency Department staff soon found the reason for the man’s headache; a large iron nail lodged in the patients head, which seems to have been hammered into the patient’s skull from the top down. OUCH!
The weird part is that he has no memory of how it ended up there.
He was completely conscious and didn’t have any traces of blood surrounding his wound.
He was rushed straight into a three-hour operation to remove the nail after revealing the depth of the injury in a CT scan.

Image source: medicaltalks
#17 This Will Hurt In The Morning. Penetrating Branch Root Injury In A Motorcycle Enduro Rider!
The patient was participating in an off-road motorcycle enduro race when he encountered a challenging section of the course with thick vegetation and overhanging branches.
While navigating through the uneven terrain at high speed, the patient failed to duck in time, and his left foot accidentally came into contact with a protruding branch root, resulting in a penetrating injury to the dorsal aspect of the foot, leading to soft tissue trauma and puncture wound.
Luckily, no evidence of fractures or foreign body retention after the extraction was done.

Image source: medicaltalks
#18 A Devastating Grinder Injury Of The Hand — Notice The Left Hand Caught Within The Meat Grinder!!
This 22-year-old male patient presented to the emergency department with his left hand caught in a commercial meat grinder. After partially dismantling the grinder, the patient was brought to the hospital, with the hand still trapped inside.
The patient was taken to the operating theater and given general anesthesia. A welder was brought in to cut across the thick metallic components of the grinder using a cutting torch.
After removing the outer shell, the hand was found to have extensive crush injuries. Three distinct longitudinal wounds were present over the fingers, the distal palmar crease, and the distal wrist crease, corresponding to the worm of the grinder.
No bleeding was observed from the wounds until the level of the wrist. At this point, the bones of the distal to the wrist were completely crushed, exposing the underlying tendons. After washing out the wound with povidone-iodine and saline, a disarticulation was performed at the level of the wrist.
The postoperative period was uneventful, and the patient was discharged after a day. He was followed closely in the outpatient department but refused prosthesis and reconstructive surgery for the injury.
Case by Department of Plastic and Reconstructive Surgery, Dayanand Medical College and Hospital, India.

Image source: medicaltalks
#19 A Giant Gastric Trichobezoar (Hair Ball)! A Bezoar Is A Tightly Packed Collection Of Undigested Material That Is Unable To Exit The Stomach, Most Being Hair-Trichobezoars
This 16-year-old female with a positive psychiatric history of OCD had uncontrollable repetitive thoughts with urge to pull (trichotillomania) and eat hair (trichophagia).
She presented with epigastric pain for the past six months with progressive loss of apetite and early satiety. Vomiting with increasing frequency for the last two months. Lean patient with hair cropped short.
On examination, soft, non-tender abdomen with no distention. Firm to hard mass palpable, craniocaudally extending from the below the subcostal margins to the infraumbilical region and horizontally between both midclavicular lines.
Mass was mobile and moved with respiration. No other positive findings on physical examination.
XRay Abdomen showed a radio-opaque shadow occupying most of the abdominal cavity. CECT showed a large intraluminal mass in the stomach extending up to the
second part of duodenum consistent with a gastric bezoar. Laparotomy and extraction of trichobezoar done successfully. The bezoar had formed into a cast of the stomach and the first and second parts of the duodenum. Uneventful post-op course. Patient discharged over to psychiatric care for further management.

Image source: medicaltalks
#20 What Started As A Peaceful Gardening Session Among The Blooms Quickly Became A Thorny Situation For This Nanny, As She Went To Hang Her Gardening Fork Up, It Fell And Took An Unintended Detour Into Her Hand

Image source: medicaltalks
#21 This Is A Heart-Warming Shot Of A Premature Baby Born So Tiny His Father’s Wedding Ring Fit His Forearm Like A Bracelet

Image source: medicaltalks
#22 Fisherman’s Tale: When A Hook Found A New Piercing Spot

Image source: medicaltalks
#23 A Dodgeball Injury That Resulted In Radius And Ulnar Shaft Fracture, AKA Broken Forearm
This sustained dodgeball injury has led to a bilateral diaphyseal fracture involving both the radius and ulnar shaft, thereby presenting as a fracture of the forearm.
This particular injury entails the disruptive discontinuity of the long bones situated within the antebrachial region, namely the radius and ulnar diaphyses. Etiologically, such fractures arise consequent to an abrupt forceful impact or trauma, commonly encountered within dynamic sports such as dodgeball. Timely medical intervention is imperative to accurately ascertain the nature and extent of this injury, often accomplished through radiographic imaging modalities like X-ray examinations. Treatment modalities encompass immobilization employing a cast or, in severe instances, surgical intervention to achieve anatomical alignment and biomechanical stability of the fractured bony elements.
Due to significant displacement, the initial treatment is closed reduction that is attempted when fracture angulation exceeds 10 degrees or displacement exceeds 50%.
Reduction involves placing the patient’s affected arm in finger traps while the brachium is secured with a strap or weights. This setup allows for ready manipulation of the forearm and rapid splinting once reduction is achieved. After satisfactory alignment is achieved, the fractured arm is placed in a long-arm posterior splint with the elbow at 90 degrees and the wrist in neutral (ie, without supination or pronation) and slight extension.

Image source: medicaltalks
#24 A Rare Case Of Ovarian Ectopic Pregnancy
This rare and potentially life-threatening condition, is characterized by the aberrant implantation and subsequent development of a fertilized ovum within the ovarian parenchyma.
In other words, the fertilized egg implants and develops within the ovary instead of the uterus. It occurs when the fertilized egg fails to travel down the fallopian tube and instead implants in the ovarian tissue.
Clinically, it manifests with a constellation of symptoms including abdominal pain, frequently localized to one side, and vaginal bleeding. The symptomatology may demonstrate variable intensity, while concurrently mimicking other gynecological conditions, thereby precipitating diagnostic challenges and potential delays in appropriate management.
Diagnostic modalities encompass the utilization of transvaginal ultrasonography, which reveals the presence of a gestational sac within the ovarian milieu. Additional sonographic findings may encompass adnexal masses, augmented vascularity within the ovarian bed, or the absence of a gestational sac within the uterine cavity. Serial monitoring of serum human chorionic gonadotropin (hCG) levels contributes to the diagnostic algorithm, facilitating the assessment of pregnancy progression and viability.
Surgical intervention is frequently preferred and is typically accomplished through laparoscopic means, which confer enhanced visualization and precision in the removal of the ectopic pregnancy while minimizing collateral ovarian damage. However, instances necessitating extensive ovarian involvement or situations wherein laparoscopic proficiency is limited may necessitate recourse to laparotomy. The overarching goal of surgical intervention is the complete eradication of the ectopic pregnancy while preserving the functional integrity of the ovarian tissue.
Alternatively, selected cases may be amenable to medical management, wherein the administration of methotrexate, a folic acid antagonist, retards the growth of trophoblastic tissue, facilitating gradual resorption of the ectopic pregnancy by the body.

Image source: medicaltalks
#25 Child Mouth Before Loosing Their Teeth

Image source: medical_pedia
#26 56 Year Old Patient With Severe Toe Misalignment Due To Rheumatoid Arthritis, Before And After Surgery
56 year old patient with severe toe misalignment due to rheumatoid arthritis, before and after surgery!
Rheumatoid arthritis is a chronic disease that attacks multiple joints throughout the body. It most often starts in the small joints of the hands and feet, and usually affects the same joints on both sides of the body.
More than 90% of people with rheumatoid arthritis (RA) develop symptoms in the foot and ankle over the course of the disease.
The joints of your body are covered with a lining — called synovium — that lubricates the joint and makes it easier to move. Rheumatoid arthritis causes an overactivity of this lining. It swells and becomes inflamed, destroying the joint, as well as the ligaments and other tissues that support it. Weakened ligaments can cause joint deformities — such as claw toe or hammer toe. Softening of the bone (osteopenia) can result in stress fractures and collapse of bone.
Fusion of the affected joints is the most common type of surgery performed for RA. Fusion takes the two bones that form a joint and fuses them together to make one bone.
During the surgery, the joints are exposed and the remaining cartilage is removed. The two bones are then held together with screws or a combination of screws and plates. This prevents the bones from moving.
Because the joint is no longer intact, this surgery does limit joint motion. Limited joint motion may not be felt by the patient, depending on the joints fused. The midfoot joints often do not have much motion to begin with, and fusing them does not create increased stiffness.

Image source: medical_pedia
#27 A Blood Clot Coughed Up By A Patient, That Perfectly Shaped The Lung’s Cavity It Filled
This huge blood clot took the shape of the bronchial tree. This photo shows the most visually arresting medical anomalies. The image is of a mysterious, branchlike structure that, posted elsewhere, would probably pass for a cherry-red chunk of some underground root system or a piece of bright reef coral. But this is no creature of the deep. It’s a completely intact, six-inch-wide clot of human blood in the exact shape of the right bronchial tree, one of the two key tubular networks that ferry air to and from the lungs. And it was coughed up in one piece. This cast was produced by a 36-year-old man who was admitted to the intensive care unit with an acute exacerbation of chronic heart failure. His medical history included heart failure with an ejection fraction of 20%, bioprosthetic aortic-valve replacement for bicuspid aortic stenosis, endovascular stenting of an aortic aneurysm, and placement of a permanent pacemaker for complete heart block. An Impella ventricular assist device was placed for management of acute heart failure, and a continuous heparin infusion was initiated for systemic anticoagulation. During the next week, the patient had episodes of small-volume hemoptysis and increasing respiratory distress. During an extreme bout of coughing, the patient spontaneously expectorated an intact cast of the right bronchial tree. Terrifying as it is, it’s a fascinating illustration of the anatomy of the right bronchial tree, which consists of three segmental branches in the upper lobe (blue arrows), two segmental branches in the middle lobe (white arrows), and five segmental branches in the lower lobe (black arrows).

Image source: medical_pedia
#28 Surgical Correction Of Congenital Cleft

Image source: medical_pedia
#29 Extreme Case Of Craniofacial Fibrous Dysplasia
Craniofacial fibrous dysplasia is a bone disease of the face and skull that replaces normal bone with fibrous-type tissue. This tissue is not as hard as normal bone, and because it is soft and stringy, and as these areas of fibrous tissue grow and expand over time, it makes the bone more fragile, prone to break, and eventually become deformed. Craniofacial fibrous dysplasia may cause shifting of facial features and facial asymmetry, such as incorrect placement of the eyes, misalignment of the jaw, and other problems. It may appear in childhood, usually between the ages of 3 and 15. Boys are more often affected. Surgical treatment is usually required. Most cases of craniofacial fibrous dysplasia manifest as swellings that cause facial deformity and surgical recontouring after cessation of growth seems to provide the best results.

Image source: medical_pedia
#30 “Ei-Ffel”. This Is The Actual Photo Of Yesterday’s Case Showing An Eiffel Tower Miniature Embedded Into The Foot

Image source: medical_pedia
#31 A Newborn With A Giant Teratoma Of The Right Orbit Saved By Embolisation And Surgery
Orbital teratomas are rare, usually benign congenital tumors, with about 70 cases reported in the English literature. Clinically, the tumor presents in healthy newborns with rapid growth, extreme unilateral proptosis and marked stretching of the eyelids over a tense, fluctuating mass, with elongation of the palpebral fissure and transillumination of all or part of the orbital mass. The persistent enlargement of this neoplasm is attributed to mucus secretion from the embryonic intestinal tissue. In this case, cyanoacrylate glue embolisation of the ophthalmic artery, using an umbilical catheter, followed by orbital xenteration under general anaesthesia was performed at 7 hours of life. Surgery was achieved in less than 2 hours with no bleeding, especially after sections of oculomotor muscles and optic nerve. Dilated skin tissue was long enough to heal the whole orbital cavity, and postoperative care has been uneventful after a follow-up of two years. Credit: Journal Français d’Ophtalmologie Volume 40, Issue 4, April 2017.

Image source: medical_pedia
#32 Reaching For Life! This Image Depicts A Deeply Moving Moment Of A Preterm Baby, Born At Just 24 Weeks Gestation And Weighing 570 Grams
Babies born this early are considered micro-preemies, facing extraordinary challenges, as they are highly vulnerable to numerous complications due to underdeveloped organs and systems. The image, showing a tiny hand reaching out, reflects the fragility and resilience of life in its earliest and most vulnerable state.
At 24 weeks, the lungs, brain, and digestive system are not fully developed, requiring intense medical intervention in a neonatal intensive care unit (NICU). This baby is likely receiving life-sustaining support, including mechanical ventilation or continuous positive airway pressure (CPAP) for immature lungs, intravenous nutrition, and possibly phototherapy for jaundice. Every day is critical for a micro-preemie like this, with survival dependent on advanced neonatal care and the gradual maturation of vital organs.
Despite the overwhelming challenges, the hand reaching out is a symbol of hope—a testament to the potential for survival and the tireless efforts of healthcare professionals in the NICU to provide this baby the best chance at life.

Image source: medicaltalks
#33 An En-Caul Birth On The Road!! Here’s An Incredible Birth Story Of A Baby Born Still Enclosed Within The Amniotic Sac
“The human body is truly an amazing thing. 8.5.2017 at about 10am I started having contractions. I was only 29 weeks and 4 days so I just figured they were Braxton hicks and decided to wait it out. After about 45 minutes of consistent contractions that were increasing in intensity I decided I should probably go in. I there in some clothes. Grabbed my daughter some clothes, her my fiance And I left for the hospital. I dropped my daughter to her God mommy Nicole And headed to the hospital. Well the contractions continued to get closer together and more intense and before I knew it I knew it was time to push. I called 911 because I was so scared. They couldn’t understand me between the screams with contractions. So I handed the phone to my fiance.
I pulled my pants off and reached down, sure enough his head was right there. I pushed one time and my miracle baby was here. When I looked down I realized he was still completely wrapped in the amniotic sac. The dispatcher told us to pull over. But I knew we would make it to the hospital before they would make it to us. So I told Ean to keep driving. I was so scared. My Fiance was so calm driving and on the phone with 911. At first the baby was still and all I could do was pray he would be okay. And then I rubbed his face with my thumb and he pulled his little hands and feet up to his face as if he understood my prayers and wanted to reassure us he was okay. About 7 minutes passed that I held this miracle baby in my hands until we made it to the hospital. A familiar face came running out and grabbed my baby. He was born an caul. This happens 1 in every 80,000 births. Usually during c-section. He was 3lb 1oz. He doing wonderful all things considered all He went through I know he’s going to be an awesome little man! ❤ he is truly a miracle baby. We are so blessed to be his parents.”

Image source: medicaltalks
#34 Laser Tattoo Removal Gone Wrong — Huge Blisters Containing Ink While Removing Tattoos
Tattoos consist of thousands of large particles of pigment suspended in the skin, hence, laster tattoo removal works by breaking down those ink particles.
In laser tattoo removal, the laser emits high-energy pulses targeted at the tattoo ink, causing it to fragment into smaller particles that the body can eliminate. The intense heat generated (thousands of degrees) during this process may result in thermal injury to the surrounding skin, prompting an inflammatory response. Blisters may form as a consequence of increased permeability and fluid accumulation in the epidermal and dermal layers.
Essentially the blisters are containing ink, blood and water as the laser heating up the ink particles in the skin which can then cause blood vessels surrounding the tattoo to rupture.
Proper post-procedural care, including wound management and infection prevention, is essential to support optimal healing and reduce the risk of complications.

Image source: medicaltalks
#35 The Human Body Is Truly Amazing. This Photo Shows You A Rare Glimpse At Something That’s Called Fascia, It’s The White Covering That Is On Top Of Muscle And Under The Skin
Fascia is a layer of connective tissue below the skin. It surrounds and holds every organ, blood vessel, bone, nerve fiber and muscle in place. The tissue does more than provide internal structure; fascia has nerves that make it almost as sensitive as skin.
Fascia can be broken down into four main layers: superficial, deep, visceral, and parietal.
Superficial fascia is right under the skin. It’s thicker in the main part of the body (stomach, chest, etc.), and it gets thinner in places further away, like in the hands and feet.
Deep fascia covers bones, muscles, nerves, and blood vessels.
The visceral fascia layer goes around certain organs that settle into the body’s open spaces, including the lungs, heart, and stomach.
The injury in this case was caused by a screw bolt that was sticking out of a stove! The patient was injured when he pushed a stove off of a dolly that was about to fall on a coworker. He saved the coworker from harm, but unfortunately was cut on the arm in the process by a bolt sticking out of the stove. Resulting in the injury shown in the photos. The last photo shows the scar healed one year after the injury.

Image source: medicaltalks
#36 Nope, That’s Not A Funny Looking Prosthetic On Her Left Leg… That’s A Gangrenous Foot With A Leg Down To The Bone
This 23 year old female developed gangrene to her left foot secondary to peripheral artery disease (PAD), which is most commonly caused by diabetes and poor diet!
At the initial visit, she refused treatment as she wanted a more holistic, rather than western, medical approach. She went to a spiritual treatment church for 4 months and came back to the clinic with the above leg. The infection continued to grow, and the bacteria ended up eating the tissue just below the knee. I hate to break it to you people, but holistic treatments do not work for acute issues.
Do we think there is a place for alternative medicine, of course we do! However, this is not a treatment for an acute cause. The herbal treatments would not do shit for a bacterial infection, such as a cellulitis. You can criticize that belief, but are many people come in saying “I treated my UTI with an holistic medicine”, but they have not gotten better. This is because they are treating symptoms rather than attacking the infection at the source, the bacteria. Unfortunately, the alternative method cannot match against an antibiotic when attempting to rid an infection. All in all, we do believe that there are significant uses for holistic approaches to medical treatments. However, you cannot believe that holistic methods should be used as alternatives to the Western medical treatments that have scientific merit when treating specific diseases.

Image source: medicaltalks
#37 This Man Miraculously Survived Being Impaled By A 40-Pound Piece Of Farm Equipment
The 43-year-old man in this mind-boggling case was building a fence when a hay bale spear attachment fell off a loader. It pierced his back and went out through his stomach.
“I felt something hit me and I went to the ground, I looked up and I was looking around to find out what had happened, and I saw that belt tine sticking through me and into the ground.”
Since the spear, which weighed 40 pounds, was still attached to the machine when it went through his body, his coworkers had to cut it off from the loader with a heat torch.
He was flown to a medical centre and underwent a four-hour operation to remove the spear and repair internal injuries.
The object missed his spinal cord, his aorta and it missed the ureter — the tube connecting his kidney to his bladder by a few centimeters.
The patient was discharged only 2 weeks after the accident and is expected to make a full recovery.
While you would expect an accident like this to cause immediate death, some lucky people have been known to survive. If the object happens to miss vital organs, arteries or your spinal cord, doctors may be able to remove it and repair internal damage quickly enough to keep the patient alive.”
He did make an extraordinary recovery.

Image source: medicaltalks
#38 A Fetus In It’s Intact Amniotic Membrane

Image source: medical_pedia
#39 Cystic Hygroma It Is A Fluid-Filled Sac Due To Blockage Of The Lymphatic System That Appears As A Swelling Usually In The Neck
They are present in neonates or infants but they may also be present prenatally and at birth they may become large enough to cause obstructed labor. The swelling is translucent, usually bilateral, soft and partially compressible and it’s size increases when the child cries or coughs. The swelling can sometimes become so large that it causes respiratory problems and feeding difficulties which makes it difficult for the child to thrive. The cyst can also become infected if not treated. The only definitive treatment is complete excision of the cyst when it is at an early stage. However, it is essential that no residual tissue is left behind otherwise it may recur

Image source: medical_pedia
#40 Heart Valve

Image source: medical_pedia
#41 This Is Why Many Peoples’ Nightmares Contain Spiders. An Extreme Case Showing Brown Recluse Spider Bite Of The Thumb

Image source: medical_pedia
#42 A Mega-Size Globular Heart!! This Very Large Heart Has A Globoid Shape Because All Of The Chambers Are Dilated. It Felt Very Flabby, And The Myocardium Was Poorly Contractile

Image source: medical_pedia
#43 Cross Section Of The Lungs Of A Patient With Copd (Emphysema , Chronic Bronchitis And Asthma)

Image source: medical_pedia
#44 Consequence Of Multiple Dog Bites! Bites And Maulings By Dogs, Sometimes Fatal, Are A Worldwide Problem And Particularly Affect Children

Image source: medicaltalks
#45 This Is The Femur Of A 10-Year-Old Boy With Ewing’s Sarcoma After Treatment With Liquid Nitrogen
This patient underwent limb salvage therapy with biological reconstruction.
The femur was removed, treated with liquid nitrogen to kill remaining tumor cells, and then reimplanted. The series of images illustrates the surgical process and post-surgical radiographs.
After surgery, recovery in the ICU and chemotherapy, the patient can now ride a bike again.
Ewing’s Sarcoma is an undifferentiated neoplasm that is part of the Ewing Tumor family, derived from embryonic cells that migrated from the neural crest. The most common locations are the pelvis and proximal long tubular bones (such as femur, tibia and humerus) especially around the growth plates.
30% are overtly metastatic at presentation.
Presentation is non-specific with patients experiencing extreme local bone pain, being by far the most common symptom, with a soft tissue mass being palpated occasionally.
Swelling is most likely to be visible if the sarcoma is located on a bone near the surface of the body, but when it occurs in other places deeper in the body, like on the pelvis, it may not be visible.
A typical “onion skinning”-type pattern is often seen on x-rays.
Mutation wise, a genetic chromosomal translocation t(11;22) which leads to expression of fusion protein EWS-FLI1 is found in around 90%.
Almost all patients require multidrug chemotherapy as well as local disease control with surgery and/or radiation.

Image source: medicaltalks
#46 This Is An Extreme Case Of Hangnail

Image source: medicaltalks
#47 But With A Sprinkle Of Imagination We Can All Assume What Happened Here. This Was Extracted As A Whole, Let’s Just Agree That Working In A Hospital Isn’t For The Faint Hearted

Image source: medicaltalks
#48 Putting That Skull Back In, Just Like A Puzzle!
The following picture shows the process of placing back a temporarily removed part of the skull, called craniotomy.
Craniotomy involves the removal of a segment of the cranium to gain access to the intracranial contents for brain surgery.
After a scalp incision is made, a burr hole is created using a high-speed drill. This allows for the removal of a bone flap, which is carefully preserved.
Following the bone flap removal, the dura mater is typically incised, providing access to the brain. Various surgical techniques are employed, depending on the specific pathological condition being addressed. These may include tumor resection, hematoma evacuation, arteriovenous malformation excision, or the placement of intracranial monitoring devices.
After the necessary intervention is completed, the dura mater is sutured or sealed using synthetic materials. The bone flap is then repositioned and secured using titanium plates, sutures, or wire mesh. The bone will eventually re-grow and the skull will be fully continuous again.
In certain cases, when the bone flap cannot be reattached, alternative synthetic materials (like a titanium mesh) may be used to reconstruct the cranial defect and replace the bone flap if it cannot be reattached.

Image source: medicaltalks
#49 A Drug With A Nasty Bite, Here’s A Close-Up Of A Krokodil-Induced Skin Necrosis In An Iv Drug User

Image source: medicaltalks
#50 Avocado Slicing Injuries Are On The Rise Due To Lack Of Handling Skills
Avocado slicing injuries are on the rise due to lack of handling skills. This patient accidentally stabbed her hand while trying to cut an avocado and remove the pit. Guess it’s simply a matter of the knife slipping.
The patient used the knife to split an avocado in half and then tried to get the stone out with a spoon but with no luck. She put the knife in to the pip and turned it clock wise to prise it out but had no luck, so she put the knife under the pip to dig it out and pushed to far.
Avocado is one of the most popular brunch items – but the task of removing the pit due to lack of handling skills is proving to be a real kitchen hazard.
Classically, patients hold the avocado in their non-dominant hand while using a knife to cut/peel the fruit with their dominant hand.
The mechanism of injury is usually a stabbing injury to the non-dominant hand as the knife slips past the stone, through the soft fruit.
These stabbing injuries have the potential to cause significant neurovascular, tendinous and/or bony injuries.

Image source: medicaltalks
#51 Degloving Injury After Hand Got Caught At A Factory Machine!! Literally Came Off Like A Glove
This 38-year-old male patient presented to the emergency department after getting his hand crushed and degloved in a heavy equipment machine at the factory he works.
Notice the extensive section of skin that got completely torn off the underlying tissue, severing its blood supply. De-gloving injury is named by analogy to the process of removing a glove. As simple as it sounds.
The patient underwent emergency surgery, and replantation was performed with the assistance of a microscopic magnification.
Formal replantation (re-attachment) involves debridement (removal of dead or contaminated tissues), repair of the underlying tendons and muscles if injured, and revascularization of the degloved skins, or when these are not possible, skin grafts or skin flaps.
This requires VERY delicate instruments and working hands.
Due to poor blood circulation and extent of the trauma the vasculature, the middle and distal phalanges of the index finger were amputated.

Image source: medicaltalks
#52 A 15 Year Old Male With A Foreign Body – Wounded By A Wood Splinter
An impalement injury is a traumatic condition characterized by the penetration of a foreign object into the body.
In the specific case mentioned, a segment of wood penetrated the soft tissues of the right foot, specifically entering the interdigital space between the fourth and fifth toes.
This patient presented to the emergency department with an 11cm long piece of wood embedded in his right foot.
He was playing on a dock of a lake in Miami, when he tried jumping into the water, the wood sticking out of the dock penetrated the skin entering between the right foot’s fourth toe and the pinkie toe area.
Luckily, there was no damage to nerves, ligaments or vessels. The object was found just under the skin and was surgically pulled out in one piece with the foot being under local anesthetics.

Image source: medicaltalks
#53 Always Careful When Stepping. This Patient Stumbled And Accidentally Stepped On A Cuticle Clipper!! You Don’t Have To Be Sharp To Know That This One Hurt
While walking barefoot in the shower room, this patient got distracted for just a second, and the next thing he knows this clipper went right through his foot with its top and sharp edge lodged into the plantar aspect or sole of his left foot.
Luckily, he had surgery and recovered totally, but not sure he’ll enjoy the showering again.

Image source: medicaltalks
#54 Ring Got In Contact With A Car Battery, Causing Circumferential Burn To The Fourth Finger!
Luckily the finger recovered, the injured skin was covered with a skin graft, but due to injured digital nerves, sensations were lost.
Electrical burns associated with rings are usually deep second-degree burns which may leave scars, cause loss of hair follicles and sweat glands, leave permanent skin pigmentation and may need skin grafting. The outcome depends on the severity of damage to the underlying tissue especially digital blood supply.

Image source: medicaltalks
#55 Screw To The Eye! Ouch. An Unfortunate Accident Of A 3 Year Old Boy With A Screw Penetrating His Left Eye After Lawnmower Spits Out Bolt!!
His dad was using the petrol-powered tool which was slung over his shoulder when the accident happened.
As he mowed the grass, the blade struck a one-inch long metal screw hidden in the lawn.
The piece of metal flicked into the air and flew straight into the toddler’s eyeball.
Doctors found that miraculously the screw missed the cornea and retina. X-rays also reveal just how deep the piece of metal became lodged into his eye socket – almost reaching the skull.
Doctors performed successful surgery to remove the screw.
The ophthalmologist that did the operation said that they will check the wound over the coming days but they are confident the boy will be able to see again.
He said: “Fortunately, the screw struck his eyeball but did not go into the lens, which thankfully has spared his sight.
“However, due to the accident his eye bled badly and now is still bloodshot so there will be follow up treatment to help the boy see again.
‘’We’re pleased with the outcome of the surgery. If the screw had been slightly to the left he would have been blinded.’’

Image source: medicaltalks
#56 Finger Was Forced Into Lateral Deviation And Dislocated Acutely During An Expedition

Image source: medicaltalks
#57 A 20-Year-Old Man Was Subjected To High-Voltage Electric Burn
The patient was admitted to a military medical complex 12 days after the accident had happened. The patient had a 40% total body surface area burn involving the upper limbs, anterior and posterior trunks, and the left thigh (third- and fourth-degree burns).
The first photo shows the patient on table just before the first operation (mummified right hand and distal forearm, anterior trunk, and lower posterior trunk show third- and fourth-degree burns with severed tissues.
The aim was to stabilize the patient by conducting lifesaving operations in multiple scheduled sessions, bilateral below-elbow amputations, escharotomies, and excision of affected ribs and cartilages. A left latissimus dorsi flap was used to cover the left side of the anterior chest wall. Skin grafting (split thickness) was done to cover the raw areas. Multiple aggressive operations by a multidisciplinary team saved the patient’s life.
Last photo shows the patient just before being discharged and with wounds totally healed.

Image source: medicaltalks
#58 Compartment Syndrome From Snake Bite
Snake bites can lead to various complications, one of the most severe being compartment syndrome. This condition occurs when increased pressure within a muscle compartment compromises blood flow, leading to tissue damage and potentially permanent disability if not promptly treated.
Compartment syndrome is a painful condition caused by increased intracompartmental pressure, compromising perfusion and resulting in muscle and nerve damage within that compartment, resulting in edema of the muscle. Because many muscles are encased in an inelastic, fascial compartment, edema increases the volume, and ultimately the pressure, within the compartment. As the pressure builds up, muscle perfusion decreases, resulting in further ischemic injury, which worsens the edema.
Compartment syndrome following a snake bite is a result of venom toxicity and tissue swelling. When a snake injects venom into its victim, the toxins can cause significant local tissue damage, inflammation, and swelling. This swelling within the confined space of a muscle compartment can quickly elevate pressure, impeding blood flow and depriving tissues of oxygen and nutrients.
Symptoms include severe pain that worsens with movement, swelling, numbness or tingling, and tightness or hardness of the affected area. In the case of a snake bite, these symptoms may develop rapidly and require immediate medical attention.
Early recognition and intervention are crucial in managing compartment syndrome. Treatment involves measures to relieve pressure within the affected compartment, such as fasciotomy—a surgical procedure to release the tight fascial compartments and relieve pressure.
It involves making incisions in the fascia surrounding the affected muscles to release built-up pressure, allowing blood flow to return to normal and preventing tissue damage.

Image source: medicaltalks
#59 Hearts Are Forever Glorious. With Both The Profoundest Power And Fragility, The Reactions Of The Human Heart Are Not Mechanical And Predictable But Infinitely Subtle And Delicate

Image source: medical_pedia
#60 Here Is A Great Shot Showing The Brain With Its Covering Layer
Below the skull and around the spinel cord are three special coverings called the meninges. You may have heard of the illness called meningitis. Meningitis is an infection of the meninges.
The outer layer of the meninges is called the dura mater or just the dura. The dura is tough and thick andit can restrict the movement of the brain within the skull. This protects the brain from movements that may stretch and break brain blood vessels.
The middle layer of the meninges is called the arachnoid. Underneath the arachnoid is a space known as the sub-arachnoid space. It contains cerebrospinal fluid, which acts to cushion the brain.
Small projections of arachnoid mater into the dura (known as arachnoid granulations) allow CSF to re-enter the circulation via the dural venous sinuses.
The inner layer, the pia mater, is located underneath the sub-arachnoid space.It is very thin, and tightly adhered to the surface of the brain and spinal cord. It is the only covering to follow the contours of the brain (the gyri and fissures).
Like the dura mater, it is highly vascularised, with blood vessels perforating through the membrane to supply the underlying neural tissue.

Image source: medical_pedia
#61 Left Ventricular Assist Device, AKA The Pump! Cardiac Transplantation Is An Option For Patients With Severe Heart Failure, And A Left Ventricular Assist Device, Or Lvad, May Help To Bridge A Patient While Awaiting Transplantation

Image source: medical_pedia
#62 Uterus

Image source: medical_pedia
#63 This Case Involves A Malfunctioning Piece Of Machinery That Shot A Metal Washer Into A Workers Eye
Unfortunately he was not wearing any eye protection or safety glasses at the time of the incident. Luckily the man was taken to a hospital and the foreign body was safely removed. He did not have any long term effects or vision loss. Even though this man was extremely lucky to have no lasting damage, vision loss and eye injury are very common with Intraocular injuries. Always remember to protect your eyes wear safety glasses!

Image source: medical_pedia
#64 They Surely Removed All His Teeth! Ostectomy Of Maxillary And Mandibular Alveolar Ridge, With Removal Of Entire Dentition – In Preparation For Full-Mouth Implants

Image source: medical_pedia
#65 Interesting Case Of A Child Presenting With Multiple Cutaneous Infantile Hemangiomas Doing Kangaroo Care
Interesting case of a child presenting with multiple cutaneous infantile hemangiomas doing kangaroo care!! A hemangioma is a bright red birthmark that shows up at birth or in the first or second week of life. They looks like a rubbery bump and proliferate both through the growth of existing vessels as well as de novo blood vessel formation. Infantile hemangiomas are benign vascular neoplasms that are the most common head and neck tumors of infancy, characterized by a period of growth after birth and eventual spontaneous involution. They can occur virtually anywhere, but the majority are found in the head and neck regions. Although most hemangiomas are benign and require no intervention, but intervention is warranted for large disfiguring lesions or lesions that impair vital functions. They are characteristically small or absent at birth. During the first year of life, they have a proliferative phase with progressive enlargement, followed by a stationary period, and finally, a progressive involution that happens during the early childhood. Up to 50% involute by 5 years and 70% by the age of 7 years. Cutaneous hemangiomas can present as blanching skin lesions that develop fine telangiectasias and can appear as a red macule with a blanching halo before they involute. Deep or subcutaneous hemangiomas may appear as bluish nodules or plaques. Extra-cutaneous hemangiomas present as lumps. Many hemangiomas disappear by age 5, and most are gone by age 10. The skin may be slightly discolored or raised after the hemangioma fades away. If treatment is to be enacted, options include anti-angiogenesis medications such as propranolol, embolization, sclerotherapy, radiotherapy, cryotherapy, laser therapy, and surgical excision.

Image source: medical_pedia
#66 This Is Oral Candidiasis, Also Called Oral Thrush, Which Is Caused By A Fungal Infections Involving The Skin And Mucous Membranes

Image source: medical_pedia
#67 Active Pulmonary Tb, Infiltrates Or Consolidations And/Or Cavities Are Often Seen In The Upper Lungs With Or Without Mediastinal Or Hilar Lymphadenopathy

Image source: medical_pedia
#68 Heart

Image source: medical_pedia
#69 A Plastinated Display Of The Fine Mesh Of Blood Vessels That Supply The Human Heart

Image source: medical_pedia
Follow Us






